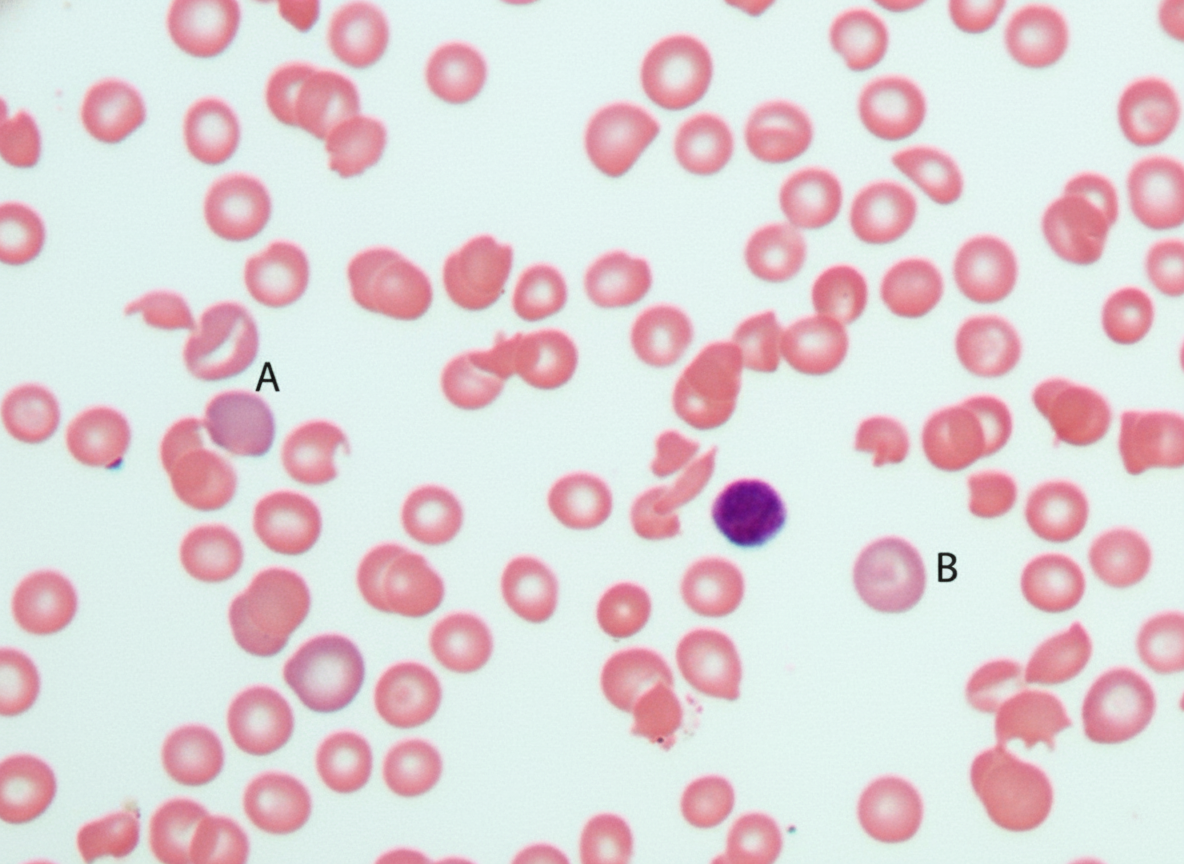
Image for question 707

Megaloblastic anemia develops in which of the following conditions?
A patient with cirrhosis of the liver has the following coagulation parameters: Platelet count 2,00,000, Prothrombin time 25s/12s, Activated partial thromboplastin time 60s/35s, and thrombin time 15s/15s. Which of the following laboratory findings can also be seen in this patient?
All of the following are poor prognostic factors in a case of acute myeloid leukemia, except?
ADAMTS deficiency is seen in which condition?
Which one of the following is not a feature of multiple myeloma?
Which of the following is a true statement regarding leukemia?
A 27-year-old black man develops sudden intravascular hemolysis 2 days after receiving the antimalarial drug primaquine, resulting in a decreased hematocrit, hemoglobinemia, and hemoglobinuria. Examination of the peripheral blood film is given. What is the most likely diagnosis?
Richter transformation in Chronic Lymphocytic Leukemia (CLL) transforms into which of the following?
What is an evidence that splenectomy might benefit a patient with idiopathic thrombocytopenic purpura?
Autosplenectomy is a condition characterized by the spleen becoming non-functional or absent. In which of the following conditions is autosplenectomy most commonly seen?
Anemia Evaluation and Management
Practice Questions
Hemoglobinopathies
Practice Questions
Thalassemias
Practice Questions
Platelet Disorders
Practice Questions
Coagulation Disorders
Practice Questions
Thrombotic Disorders
Practice Questions
Leukemias
Practice Questions
Lymphomas
Practice Questions
Multiple Myeloma and Plasma Cell Disorders
Practice Questions
Myeloproliferative Neoplasms
Practice Questions
Transfusion Medicine
Practice Questions
Hematopoietic Stem Cell Transplantation
Practice Questions
Get full access to all questions, explanations, and performance tracking.
Scan to download app